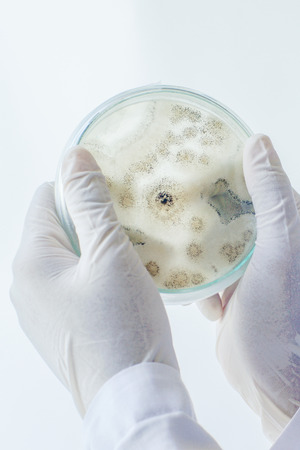
Scientist show colony of fungus (Asperillus niger) in culture medium plate, Microbiology.の写真素材

写真素材 - Scientist show colony of fungus (Asperillus niger) in culture medium plate, Microbiology.
作品情報
Scientist show colony of fungus (Asperillus niger) in culture medium plate, Microbiology.
- ID:81290376
- 作品種別:写真
- 作者名:Puntasit Choksawatdikorn
キーワード
- agar
- allergy
- analysis
- background
- bacteria
- bacterium
- biological
- biology
- biotechnology
- cells
- chemical
- colony
- contamination
- culture
- danger
- disease
- dish
- equipment
- experiment
- fungal
- fungi
- fungus
- growth
- health
- hyphae
- infection
- inoculation
- lab
- laboratory
- medical
- medicine
- micro
- microbiology
- microorganism
- mildew
- mold
- mould
- organism
- research
- sample
- science
- scientific
- spores
- surface
- test
- toxic
類似作品
Trametes versic...
close-up of mag...
effect of magic...
Mushroom family...
professional gr...
A group of mush...
Mushrooms on th...
Colorful mushro...
close-up of bio...
Tree mushrooms ...
Mysterious mush...
Trametes versic...
A group of mush...
Elvin saddle mu...
A group of mush...
Mushroom on a m...
Mushrooms growi...
Mexican Psilocy...
Many unusual ye...
Beautiful close...
A cluster of ti...
a step-by-step ...
A cluster of vi...
Generative AI :...
Person harvesti...
Tree mushrooms ...
Hiker finding p...
artistic macro ...
Glowing mushroo...
Cluster of Para...
White mushrooms...
A group of mush...
A person standi...
white mushrooms...
Mushrooms in th...
Magic Mushrooms...
tinder fungus o...
Dangerous poiso...
Earthy Mushroom...
A stunning clos...
Generative AI :...
Mushroom growin...
Mushrooms growi...
Mushrooms in th...
Magnified Marve...
mushrooms honey...
Close-up of a h...
A mushroom is s...